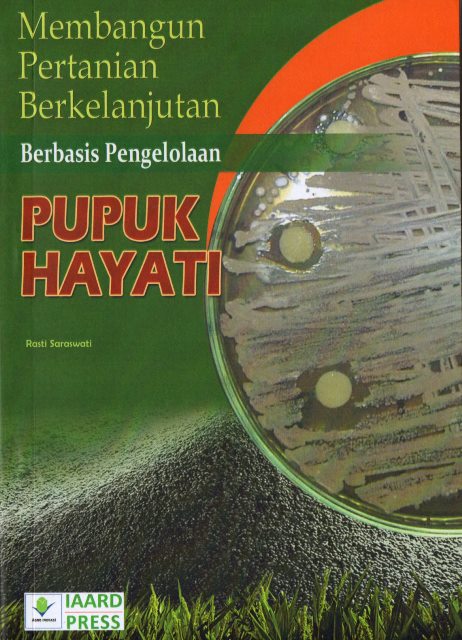

| Judul | Membangun Pertanian Berkelanjutan Berbasis Pengelolaan Pupuk Hayati / Rasti Saraswati |
| Pengarang | Saraswati, Rasti |
| EDISI | Edisi 1 |
| Penerbitan | Jakarta : IAARD Press, 2019 |
| Deskripsi Fisik | vi, 57 p. ill.; 21 cm |
| ISBN | 978-602-344-262-1 |
| Subjek | PESTICIDES HAYATI AGRICULTURAL |
| Abstrak | Buku ini menjelaskan tentang pengelolaan pupuk hayati,manfaat dan keuntungan bagi pembangunan pertanian bekelanjutan. Harapan penulis agar buku ini dapat menambah wawasan dan mendorong pengembangan pupuk hayati guna mendukung terwujudnya pertanian berkelanjutan menuju kesejahteraan petani. |
| Bahasa | Indonesia |
| Bentuk Karya | Bukan fiksi atau tidak didefinisikan |
| Target Pembaca | Tidak diketahui / tidak ditentukan |
| No Barcode | No. Panggil | Akses | Lokasi | Ketersediaan |
|---|---|---|---|---|
| 58BPV2022 | 633.18/SAR/m | Dapat dipinjam | Perpustakaan Balai Besar Perakitan dan Modernisasi Veteriner - Ruang Baca Umum | Tersedia |
| Tag | Ind1 | Ind2 | Isi |
| 001 | INLIS000000000018160 | ||
| 005 | 20220325024917 | ||
| 007 | ta | ||
| 008 | 220325###########################0#ind## | ||
| 020 | # | # | $a 978-602-344-262-1 |
| 035 | # | # | $a 0010-0322000079 |
| 082 | # | # | $a 633.18/SAR/m |
| 084 | # | # | $a 633.18/SAR/m |
| 100 | 1 | # | $a Saraswati, Rasti |
| 245 | 1 | # | $a Membangun Pertanian Berkelanjutan Berbasis Pengelolaan Pupuk Hayati /$c Rasti Saraswati |
| 250 | # | # | $a Edisi 1 |
| 260 | # | # | $a Jakarta :$b IAARD Press,$c 2019 |
| 300 | # | # | $a vi, 57 p. ill.; 21 cm |
| 520 | # | # | $a Buku ini menjelaskan tentang pengelolaan pupuk hayati,manfaat dan keuntungan bagi pembangunan pertanian bekelanjutan. Harapan penulis agar buku ini dapat menambah wawasan dan mendorong pengembangan pupuk hayati guna mendukung terwujudnya pertanian berkelanjutan menuju kesejahteraan petani. |
| 650 | # | 4 | $a AGRICULTURAL |
| 650 | # | 4 | $a HAYATI |
| 650 | # | 4 | $a PESTICIDES |
| 990 | # | # | $a 58/BPV/2022 |
Content Unduh katalog
Karya Terkait :